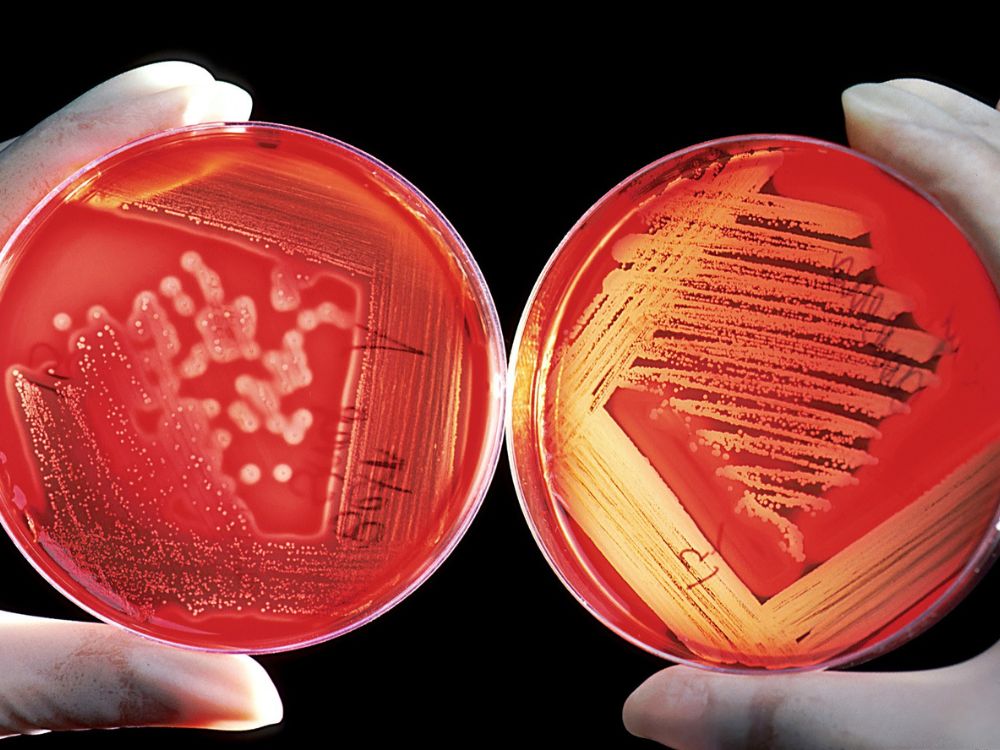
tmdt

Các Chất Dinh Dưỡng Có Trong Đông Trùng Hạ Thảo
Đông trùng hạ thảo từ lâu đã được biết đến là một loại dược liệu quý hiếm với hàm lượng dưỡng chất phong phú, có nhiều công dụng tuyệt vời cho sức khỏe. Bên trong Đông trùng hạ thảo chứa các thành phần dinh dưỡng đa dạng và quý giá, giúp tăng cường sức khỏe tổng thể, hỗ trợ hệ miễn dịch và cải thiện các chức năng cơ thể. Dưới đây là các chất dinh dưỡng chính có trong Đông trùng hạ thảo.
Các axit amin thiết yếu

Đông trùng hạ thảo chứa khoảng 18 loại axit amin khác nhau, bao gồm nhiều axit amin thiết yếu mà cơ thể không thể tự tổng hợp được như lysine, tryptophan, valine và leucine. Các axit amin này đóng vai trò quan trọng trong quá trình tổng hợp protein, phục hồi và phát triển cơ bắp, cũng như duy trì các hoạt động sinh học của tế bào.
Cordycepin và adenosine

.jpg)
Cordycepin và adenosine là hai hoạt chất quan trọng và đặc trưng có trong Đông trùng hạ thảo. Cordycepin có khả năng kháng viêm, kháng khuẩn và chống oxy hóa, giúp bảo vệ cơ thể khỏi các tác nhân gây hại từ môi trường. Adenosine có tác dụng cải thiện lưu thông máu, giúp ngăn ngừa hình thành các cục máu đông, từ đó giảm nguy cơ bệnh tim mạch và tăng cường sức khỏe tim mạch.
Vitamin và khoáng chất

Đông trùng hạ thảo cung cấp nhiều loại vitamin cần thiết cho cơ thể, bao gồm:
- Vitamin B12: Giúp duy trì hệ thần kinh khỏe mạnh, hỗ trợ sản xuất tế bào hồng cầu và giảm nguy cơ thiếu máu.
- Vitamin E: Có tác dụng chống oxy hóa, bảo vệ tế bào khỏi tổn thương và giúp làn da khỏe mạnh.
- Vitamin K: Hỗ trợ quá trình đông máu và giúp xương chắc khỏe hơn.
Ngoài ra, Đông trùng hạ thảo còn chứa nhiều khoáng chất như sắt, canxi, kẽm, và magie, rất cần thiết cho các chức năng của cơ thể.
Polysaccharides
Polysaccharides là một trong những thành phần quan trọng giúp Đông trùng hạ thảo hỗ trợ hệ miễn dịch. Chúng có khả năng tăng cường hoạt động của các tế bào miễn dịch như tế bào NK (Natural Killer) và đại thực bào, giúp cơ thể chống lại vi khuẩn, virus và các tác nhân gây bệnh khác. Bên cạnh đó, polysaccharides còn có tác dụng chống oxy hóa mạnh, giúp giảm quá trình lão hóa và bảo vệ các tế bào khỏi tổn thương.
Sterols (ergosterol)

Ergosterol là một loại sterol có mặt trong Đông trùng hạ thảo, có tác dụng hỗ trợ sức khỏe gan, giảm cholesterol xấu trong máu và tăng cường khả năng giải độc cho cơ thể. Ergosterol cũng được biết đến là tiền chất của vitamin D2 khi được chuyển hóa dưới ánh sáng mặt trời, giúp tăng cường khả năng hấp thụ canxi, tốt cho hệ xương.
D-mannitol
D-mannitol là một loại đường tự nhiên có tác dụng lợi tiểu, giúp thải độc và điều hòa huyết áp. Trong Đông trùng hạ thảo, D-mannitol có thể hỗ trợ trong việc làm giảm áp lực lên thận, giúp duy trì chức năng thận khỏe mạnh.
Chất chống oxy hóa
Ngoài các dưỡng chất chính, Đông trùng hạ thảo còn chứa nhiều chất chống oxy hóa khác, bao gồm các flavonoid và carotenoid, giúp bảo vệ tế bào khỏi tác động của các gốc tự do. Chất chống oxy hóa này còn có khả năng giảm viêm, cải thiện hệ miễn dịch và bảo vệ sức khỏe tim mạch, phòng ngừa các bệnh mãn tính.









.jpg)





.jpg)













